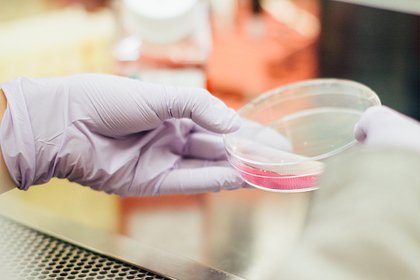

Мир
Бывшая первая леди Южной Кореи получила 7 лет тюрьмы за взятки в виде роскошных подарков
USD 75,6347 EUR 85,7697
Главная » НОВОСТИ » Здравоохранение и спорт » Ученые выяснили, что антибиотики помогают бактериям расти
27.09.2023 12:52
Ученые Эксетерского университета (Великобритания) выявили у определенных бактерий способность использовать антибиотики для роста. Результаты исследования опубликованы в журнале PNAS, пишет Lenta.ru.
Фото: Drew Hays / Unsplash
В ходе работы авторы изучили колонии E.coli (кишечной палочки). Они заметили, что обработка микроорганизмов антибиотиками, которые нацелены на рибосомы, замедляла рост бактерий, а также увеличивала их продолжительность жизни.
Ранее считалось, что антибиотики уничтожают бактерии или останавливают их рост. Однако в последнее время у некоторых бактерий наблюдается рост устойчивости к антибактериальным препаратам, поэтому многие из этих лекарств перестают действовать. Тем не менее в данном исследовании был зафиксирован иной механизм.
Оказывается, определенные антибиотики могут облегчить стресс и помочь предотвратить сокращение популяций бактерий из-за нехватки питательных веществ. То есть больше бактерий выживают по сравнению с популяциями без антибиотиков. Команда предположила, что это происходит потому, что антибиотики являются антиоксидантами. То есть они помогают клеткам справляться с некоторыми из отходов, которые они производят по мере роста. Примечательно, что у устойчивых к антибиотикам бактерий, которые тестировали в эксперименте, не было таких преимуществ.
Все права защищены. При перепечатке ссылка на сайт ИА "Грозный-информ" обязательна.
Нашли ошибку в тексте? Выделите ее мышкой и нажмите: Ctrl+Enter
Поделиться: